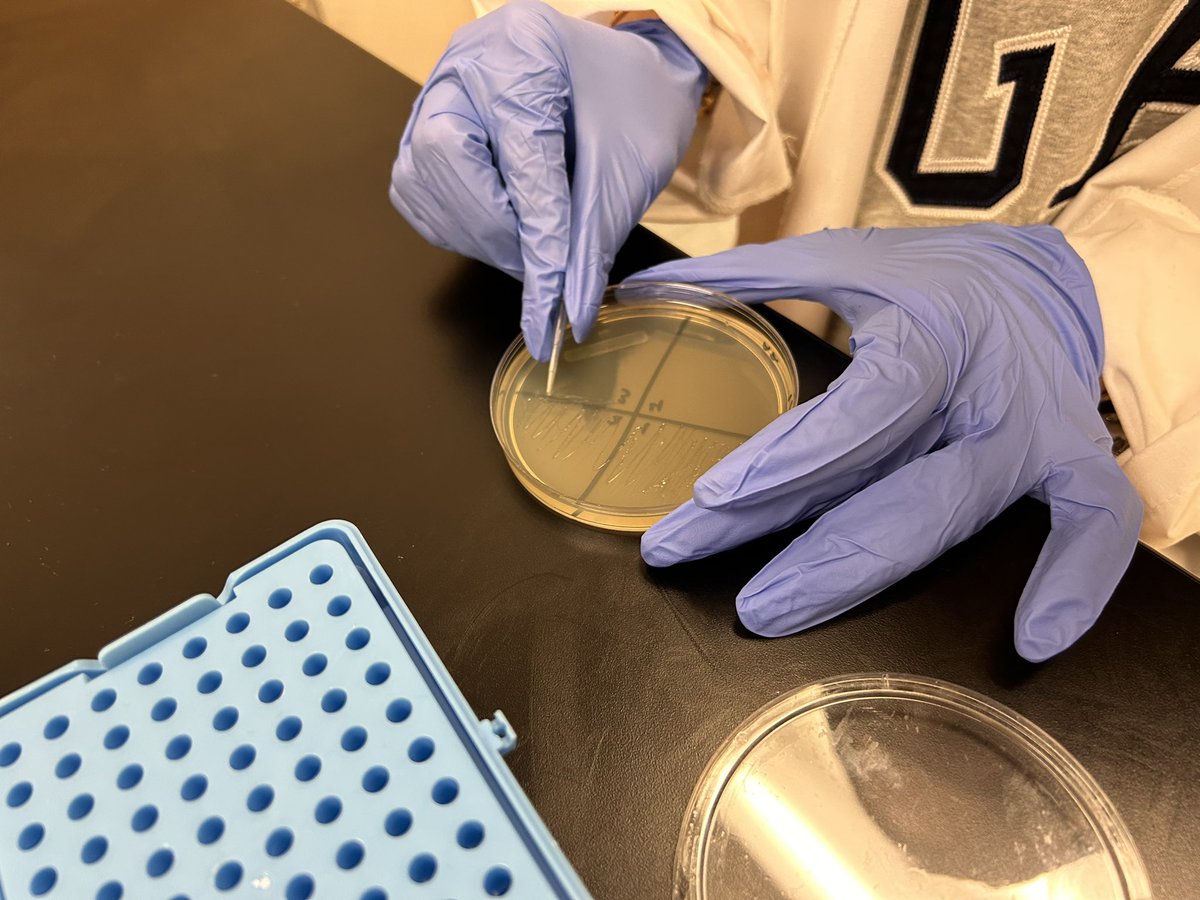
DrKeshodkarS's tweet image. Learning about microbiology and streaking bacteria plates in @PLTWorg Biomedical Science class. #futurehealthprofessionals trying to figure out the cause of the nosocomial infection!🥼🔬🧪💉🏥 @LibertyHigh @MrLittleScience @MissRichardsLHS @Leesonscience

Mr. Little
@MrLittleScience
Science Department Chair | Chemistry Teacher | Liberty High School
You might like
Huge thank you to our friends from @LVHN for sharing their career experiences with @LibertyHigh students today @MissRichardsLHS @hbailey3LHS @BethlehemAreaSD




Thank you @LVHN for hosting Liberty HS students at the Healthcare Education Center for a Mini Medical School Day! We appreciate all of the hard work put into this amazing experience! @lvhemres @DrKeshodkarS @MissRichardsLHS @MrLittleScience




Thank you @mystlukes for the 🛑 STOP THE BLEED training in my @PLTWorg Biomed class @LibertyHigh. Mrs Wilde-Onia and Ms. Robbins we loved the hands-on training and cannot wait to do this next school year!🩸💉🧬🔬🧪@Leesonscience @MrLittleScience @MissRichardsLHS @BethlehemAreaSD




Congratulation to the @LibertyHigh seniors on their @PLTWorg Biomed capstone presentations and white coat ceremony! So proud of your achievements!! 🎓🩺⚕️@hbailey3LHS @MissRichardsLHS @Leesonscience @MrLittleScience @BethlehemAreaSD




Congratulations to all students in the @LibertyHigh Engineering and BioMed @PLTWorg program who did their capstone presentations today. Job well done! @Leesonscience @basdjacksilva @BASDSUPT @BethlehemAreaSD @MissRichardsLHS @hbailey3LHS @DrKeshodkarS @engtotch




Fantastic Biomedical Science Capstone projects at Liberty High School! @BethlehemAreaSD @hbailey3LHS @MissRichardsLHS @DrKeshodkarS @ScienceMrA @MrLittleScience


Congratulations 🥳🎉🎊Camilla Robles-Rubio, Grace Daja & Declan Edwards for their accomplishments at the @PJASorg 88th State competition @penn_state #PJASstates @LibertyHigh @tarabroc @MrLittleScience @MissRichardsLHS @BethlehemAreaSD




Thank you Dr. Akusoba, Mrs. Cuda and your team for hosting @LibertyHigh @PLTWorg Biomed students at your campus and the sim center labs, Anatomage table and more @mystlukes 🩺🩻🥼🧬@Leesonscience @MissRichardsLHS @MrLittleScience @BethlehemAreaSD




So proud of LHS Science Olympiad for so many medals earned today & as they await their final team results at KU! ❤️💙🧬🔬🥼

Couldn’t be more proud of our own Mr. Little for being recognized for his dedication to our students & for his continued rigorous, inspiring instruction! @hbailey3LHS @MrLittleScience @NTsamoutalidis #basdproud youtu.be/Wa04Ckzgzjc
A conversation with BASD teachers and Superintendent Dr. Joseph J. Roy at the State of the Schools this morning. #basdproud #bethlehem #stateoftheschools

Science Olympiad @LHS_SciOlympiad READY for EPC competition! 🏆🔭⚗️🔬🧬🧫🥼🧪👩🏽🔬🧑🏽🔬@MrLittleScience @tarabroc @LibertyHigh @BethlehemAreaSD @MissRichardsLHS

More than just a @LadyCanesGBB basketball star... #BASDproud of @LibertyHigh student, Jordan Thompson on becoming a member of Educator Rising. Looking forward to supporting her on her journey. educatorsrising.org #BuildingBethlehem #BASDCareerPathways @BethlehemAreaSD


We enjoyed having @BASDSUPT visit our class. The quiz is tomorrow. See you then 😉
Congratulations 🎉🎊 to all 3 @LibertyHigh FIRST place winners🥇🏆in the Region 3 PJAS competition and for sharing and defending their research in Biochem,Physics and Math categories and advancing to the states! Penn State here we come! @tarabroc @MrLittleScience @MissRichardsLHS

Thank you reps from @bbraun_com @TyberMedical @BoschRexrothUS and @JustBornInc for participating in a discussion about Careers in STEM in the Lehigh Valley with our @BethlehemAreaSD students. @LibertyHigh @MissRichardsLHS @Leesonscience @hbailey3LHS @basdjacksilva @BASDSUPT



Learning about microbiology and streaking bacteria plates in @PLTWorg Biomedical Science class. #futurehealthprofessionals trying to figure out the cause of the nosocomial infection!🥼🔬🧪💉🏥 @LibertyHigh @MrLittleScience @MissRichardsLHS @Leesonscience

Today we were joined by Mrs. Winnie Ouma, a neurological physicians assistant from St. Luke’s! Thank you so much for speaking with us! @DrKeshodkarS @MrLittleScience @mystlukes @BASDSUPT


United States Trends
- 1. Lindsey Vonn N/A
- 2. Good Sunday N/A
- 3. Super Bowl Sunday N/A
- 4. Rickea N/A
- 5. James Pearce N/A
- 6. #Olandriax15PercentPledgeGala N/A
- 7. #Toonami N/A
- 8. #JAPANEXPOTHAILAND2026 N/A
- 9. Travis Scott N/A
- 10. Falcons N/A
- 11. Annie N/A
- 12. $BFS N/A
- 13. #BlueLock N/A
- 14. Fears N/A
- 15. Jake Paul N/A
- 16. Robot N/A
- 17. #SuperBowl2026 N/A
- 18. Izzo N/A
- 19. GM CT N/A
- 20. That's Bill Clinton N/A
Something went wrong.
Something went wrong.







































































































